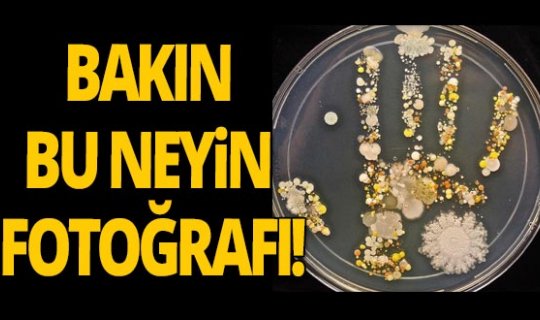
Laborant bir anne çocuğunun elinde tespit etti

Üsküdar Üniversitesi öğretim Üyesi, radyoloji uzmanı Prof. Dr. Güner Sönmez, sosyal medya hesabından paylaştığı fotoğrafla, salgın döneminde yaşadığımız hijyen umursamazlığına bir gönderme yaparak temizliğin önemini vurguladı.

Rengarenk mikrop bahçesi
Prof. Sönmez yaptığı paylaşımına, “8 yaşındaki çocuğu bahçeden döndüğünde, laborant olan annesi elini petri kabına basıyor. 2 gün sonra, üreyen organizmaların oluşturduğu bu rengarenk mikrop bahçesi meydana geliyor. El hijyeni ne kadar önemli...” yorumunu yaptı.Petri Kabı nedir?
Petri kabı, petri plakası veya hücre kültür kabı biyologların kültür hücreleri ya da küçük yosun bitkiler için kullandığı basit bir cam veya plastik silindir şeklinde, kapağı olan bir kaptır. Petri kabı, Alman bakteriyolog Julius Richard Petri tarafından Robert Koch'un asistanı olarak çalıştığı dönemde icat edilmiştir. Mucidinin adıyla anılmaktadır. Cam Petri kapları sterilize edilerek (mesela otomatik bir karıştırıcıda ya da bir sıcak hava fırını içinde 160 °C 'de bir saatlik kuru ısıtma ile) yeniden kullanılabilir. Ancak plastik Petri kapları, sterilizasyon sorunları sebebiyle genellikle tek kullanımlık olarak kullanılır.